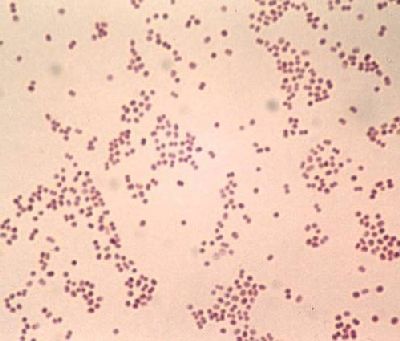

Другие названия и синонимы
Meningococcal infection.
МКБ-10 коды
- МКБ-10
- A39 Менингококковая инфекция
|
|
Описание
Менингококковая инфекция. Инфекционная болезнь, совмещающая целую группу заболеваний, которые имеют разнообразные клинические проявления - от назофарингита до менингококкового сепсиса и менингита. Объединяет их то, что все они вызываются менингококками, которые переносятся воздушно-капельным путем. Менингококковая инфекция представляет опасность, так как широко распространена, скоротечна, может вызывать тяжелые осложнения и привести к летальному исходу.
Дополнительные факты
Менингококковая инфекция. Инфекционное заболевание, имеющее типичные клинические проявления в виде поражения слизистой оболочки носоглотки. Для этой болезни характерно распространение процесса, что приводит к специфической септицемии и гнойному лептоменингиту. Менингококковая инфекция распространилась по всем странам мира, в которых наблюдаются как спорадические случаи, так и эпидемические вспышки, бывают и эпидемии. Самое большое распространение менингококковая инфекция получила в странах Центральной Африки, Южной Америки, в Китае. Вспышки этого заболевания часто возникают там, где большая скученность населения сочетается с антисанитарными условиями обитания.
В нашей стране заболеваемость менингококковой инфекцией стабилизировалась и в среднем держится на уровне 5 на 100 тысяч населения. Как показывает географический анализ, есть несколько неблагополучных зон, где показатель заболеваемости более высок. Это, в первую очередь, дальневосточные области, расположенные рядом с границей Китая и Монголии. Другой регион, который дает стабильно высокий уровень заболеваемости - Мурманская и Архангельская области.
Менингококковая инфекция характеризуется некоторой сезонностью. Число заболевших в сырое и холодное время года увеличивается, достигая пика в марте-мае. Для менингококковой инфекции типичны периодические подъемы заболеваемости, имеющие интервалы в 10-15 лет. Болезнь может поражать людей практически любого возраста, но преимущественно болеют дети. Они составляют почти 70% от общего количество всех больных. Большое значение в развитии менингококковой инфекции имеет ослабленная иммунная система человека.
В нашей стране заболеваемость менингококковой инфекцией стабилизировалась и в среднем держится на уровне 5 на 100 тысяч населения. Как показывает географический анализ, есть несколько неблагополучных зон, где показатель заболеваемости более высок. Это, в первую очередь, дальневосточные области, расположенные рядом с границей Китая и Монголии. Другой регион, который дает стабильно высокий уровень заболеваемости - Мурманская и Архангельская области.
Заражение менингококковой инфекцией.
Единственный источник возбудителя менингококковой инфекции - человек с клинически выраженными признаками болезни, а также носитель менингококков. Путь передачи менингококков - аспирационный. Распространение инфекции происходит при разговоре, чиханье, кашле, когда с капельками слизи возбудители попадают в окружающее больного воздушное пространство. Способствует заражению тесный контакт между людьми, особенно в закрытом помещении.Менингококковая инфекция характеризуется некоторой сезонностью. Число заболевших в сырое и холодное время года увеличивается, достигая пика в марте-мае. Для менингококковой инфекции типичны периодические подъемы заболеваемости, имеющие интервалы в 10-15 лет. Болезнь может поражать людей практически любого возраста, но преимущественно болеют дети. Они составляют почти 70% от общего количество всех больных. Большое значение в развитии менингококковой инфекции имеет ослабленная иммунная система человека.
Формы менингококковой инфекции.
Соответственно клинической классификации менингококковую инфекцию делят на локализованную и генерализованную. К локализованным формам относят менингококконосительство, острый назофарингит и изолированную менингококковую пневмонию. Генерализованные формы: острая и хроническая менингококкемия, менингококковый менингоэнцефалит, менингококковый менингит. Существуют редкие формы: менингококковый артрит или полиартрит, менингококковый эндокардит и иридоциклит. Частое распространение получили смешанные формы менингококковой инфекции.Патогенез
Возбудителем менингококковой инфекции является менингококк Neisseria meningitidis. Это грамотрицательный диплококк, не имеющий жгутиков и капсул и не образующий спор. Менингококки хорошо видны на окрашенных анилиновыми красками препаратах из чистой культуры. Они располагаются парно, как два боба, обращенных друг к другу вогнутой поверхностью. Оптимальная температура для роста менингококков - 37 °С. Во внешней среде они малоустойчивы, быстро погибают при воздействии солнечных лучей, дезинфицирующих средств, при высыхании и понижении температуры до 22 °С. Различают несколько серологических типов менингококков, основными из которых считаются четыре: А, в, с, D.
В результате воздушно-капельного механизма распространения инфекции менингококки проникают в носоглотку, полость рта, верхние дыхательные пути здоровых людей, затем гематогенным путем начинают распространяться в организме. В патогенезе менингококковой инфекции решающую роль играет комбинация процессов токсического и септического характера с присоединившимися аллергическими реакциями.
В результате воздушно-капельного механизма распространения инфекции менингококки проникают в носоглотку, полость рта, верхние дыхательные пути здоровых людей, затем гематогенным путем начинают распространяться в организме. В патогенезе менингококковой инфекции решающую роль играет комбинация процессов токсического и септического характера с присоединившимися аллергическими реакциями.
Клиническая картина
Инкубационный период при менингококковой инфекции длится от 1 до 10 дней, в среднем 2-3 дня. При менингококконосительстве чаще всего состояние здоровья не нарушается. Обычно болезнь начинается остро, однако у некоторых больных бывает продромальный период: слабость и потливость, головная боль и небольшое повышение температуры.
Менингококковый острый назофарингит может иметь субклиническое течение, когда отсутствуют клинические симптомы. Также он может протекать в легкой, среднетяжелой и тяжелой форме. Чаще всего встречается легкая форма назофарингита со слабой интоксикацией и субфебрильной температурой. При среднетяжелой форме температура повышается до 38-38,5 °С. У больных наблюдается такая симптоматика общей интоксикации, как головная боль и головокружение, слабость и разбитость. Наряду с этими симптомами дополнительно возникают першение и боли в горле, заложенность носа и небольшие слизисто-гнойные выделения, изредка сухой кашель. Кожные покровы обычно сухие и бледные. Тяжелое течение назофарингита проявляется высокой температурой, которая достигает 39 °С и более. Кроме головной боли наблюдается рвота, часто присоединяются менингеальные симптомы. Назофарингит нередко может предшествовать развитию генерализованных форм заболевания.
Менингококковый менингит обычно начинается остро с озноба и повышения температуры до 38-40 °С. Общее состояние больного резко ухудшается. Основной жалобой являются сильнейшие головные боли, отмечается светобоязнь. Быстро появляются и прогрессируют менингеальные симптомы. Отмечается ригидность затылочных мышц, положительный симптом Кернига и другие. Характерны двигательное беспокойство, гиперемия лица, горячая на ощупь кожа, красный дермографизм, иногда наблюдается гиперестезия кожи. Больной занимает в постели вынужденную позу, для которой характерно запрокидывание назад головы и подтягивание ног к животу.
При менингококковом менингите может наступить расстройство сознания и психические нарушения. Возможны бред, возбуждение, галлюцинации или адинамия, заторможенность, сопор, даже кома. У детей часто возникают судороги, иногда гиперкинезы. У большинства больных отмечается угнетение или усиление периостальных и сухожильных рефлексов, а также их неравномерность, происходит поражение черепных нервов. Может развиться гнойный лабиринтит, который приводит к полной потере слуха. Реже бывает неврит зрительного нерва.
Менингококкемия представляет острый менингококковый сепсис, для которого типично острое начало, высокая лихорадка, ряд септических явлений, в том числе значительные изменения в деятельности сердечно-сосудистой системы, раннее появлением сыпи и тяжелое течение. Сыпь появляется чаще на туловище и нижних конечностях в виде розеолезных и папулезных элементов интенсивно-розового или слегка синюшного оттенка. Кроме того, на коже бывают разной величины геморрагические элементы и звездчатые красные пятна, переходящие в некроз.
При менингококкемии отмечаются кровоизлияния в конъюнктивы, склеры и слизистые оболочки носоглотки. У больных могут наблюдаться носовые, маточные, желудочные кровотечения, субарахноидальные кровоизлияния, микро- и макрогематурия. В отдельных случаях возникают артриты и полиартриты. Тяжелая менингококкемия у взрослых часто сочетается с менингитом.
Менингококковый менингоэнцефалит характеризуется судорогами и нарушением сознания уже с первых дней болезни, нередко появляются зрительные или слуховые галлюцинации. Для него типичны ранние параличи и парезы.
Ассоциированные симптомы: Асимметрия суставов. Высокая температура тела. Галлюцинации. Гематурия. Гиперфибриногенемия. Головная боль. Заложенность носа. Кашель. Лейкопения. Лихорадка. Недомогание. Нейтропения. Озноб. Першение в горле. Поверхностный кашель. Потливость. Разбитость. Рвота. Судороги. Судороги в ногах.
Менингококковый острый назофарингит может иметь субклиническое течение, когда отсутствуют клинические симптомы. Также он может протекать в легкой, среднетяжелой и тяжелой форме. Чаще всего встречается легкая форма назофарингита со слабой интоксикацией и субфебрильной температурой. При среднетяжелой форме температура повышается до 38-38,5 °С. У больных наблюдается такая симптоматика общей интоксикации, как головная боль и головокружение, слабость и разбитость. Наряду с этими симптомами дополнительно возникают першение и боли в горле, заложенность носа и небольшие слизисто-гнойные выделения, изредка сухой кашель. Кожные покровы обычно сухие и бледные. Тяжелое течение назофарингита проявляется высокой температурой, которая достигает 39 °С и более. Кроме головной боли наблюдается рвота, часто присоединяются менингеальные симптомы. Назофарингит нередко может предшествовать развитию генерализованных форм заболевания.
Менингококковый менингит обычно начинается остро с озноба и повышения температуры до 38-40 °С. Общее состояние больного резко ухудшается. Основной жалобой являются сильнейшие головные боли, отмечается светобоязнь. Быстро появляются и прогрессируют менингеальные симптомы. Отмечается ригидность затылочных мышц, положительный симптом Кернига и другие. Характерны двигательное беспокойство, гиперемия лица, горячая на ощупь кожа, красный дермографизм, иногда наблюдается гиперестезия кожи. Больной занимает в постели вынужденную позу, для которой характерно запрокидывание назад головы и подтягивание ног к животу.
При менингококковом менингите может наступить расстройство сознания и психические нарушения. Возможны бред, возбуждение, галлюцинации или адинамия, заторможенность, сопор, даже кома. У детей часто возникают судороги, иногда гиперкинезы. У большинства больных отмечается угнетение или усиление периостальных и сухожильных рефлексов, а также их неравномерность, происходит поражение черепных нервов. Может развиться гнойный лабиринтит, который приводит к полной потере слуха. Реже бывает неврит зрительного нерва.
Менингококкемия представляет острый менингококковый сепсис, для которого типично острое начало, высокая лихорадка, ряд септических явлений, в том числе значительные изменения в деятельности сердечно-сосудистой системы, раннее появлением сыпи и тяжелое течение. Сыпь появляется чаще на туловище и нижних конечностях в виде розеолезных и папулезных элементов интенсивно-розового или слегка синюшного оттенка. Кроме того, на коже бывают разной величины геморрагические элементы и звездчатые красные пятна, переходящие в некроз.
При менингококкемии отмечаются кровоизлияния в конъюнктивы, склеры и слизистые оболочки носоглотки. У больных могут наблюдаться носовые, маточные, желудочные кровотечения, субарахноидальные кровоизлияния, микро- и макрогематурия. В отдельных случаях возникают артриты и полиартриты. Тяжелая менингококкемия у взрослых часто сочетается с менингитом.
Менингококковый менингоэнцефалит характеризуется судорогами и нарушением сознания уже с первых дней болезни, нередко появляются зрительные или слуховые галлюцинации. Для него типичны ранние параличи и парезы.
Ассоциированные симптомы: Асимметрия суставов. Высокая температура тела. Галлюцинации. Гематурия. Гиперфибриногенемия. Головная боль. Заложенность носа. Кашель. Лейкопения. Лихорадка. Недомогание. Нейтропения. Озноб. Першение в горле. Поверхностный кашель. Потливость. Разбитость. Рвота. Судороги. Судороги в ногах.
|
|
Возможные осложнения
Возможны специфические осложнения в раннем и позднем течении болезни. К ним относятся:
• токсико-инфекционный шок;
• острая почечная недостаточность;
• желудочно-кишечное и маточное кровотечение;
• паренхиматозно-субарахноидальное кровоизлияние;
• острое набухание и отек головного мозга;
• церебральная гипотензия;
• отек легких;
• параличи и парезы;
• гормональная дисфункция;
• эпилепсия;
• гидроцефалия.
К неспецифическим осложнениям относят такие, как герпес, отит, пневмония, пиелонефрит и другие.
• токсико-инфекционный шок;
• острая почечная недостаточность;
• желудочно-кишечное и маточное кровотечение;
• паренхиматозно-субарахноидальное кровоизлияние;
• острое набухание и отек головного мозга;
• церебральная гипотензия;
• отек легких;
• параличи и парезы;
• гормональная дисфункция;
• эпилепсия;
• гидроцефалия.
К неспецифическим осложнениям относят такие, как герпес, отит, пневмония, пиелонефрит и другие.
Диагностика
Чтобы поставить правильный диагноз, необходимо изучить клиническую картину заболевания. Принимают во внимание также эпидемиологические данные, анамнез, результаты лабораторных исследований крови и цереброспинальной жидкости, взятой путем люмбальной пункции. При подозрении на менингококконосительство или менингококковый назофарингит проводят бактериологическое исследование слизи, которую собирают с задней стенки глотки. Используют также иммунологические методы.
Дифференциальная диагностика
Дифференциальный диагноз следует проводить с другими заболеваниями. Назофарингит дифференцируют с острыми вирусными инфекциями, ангиной, фарингитом. Смешанную форму менингококковой инфекции и менингококкемию сравнивают с другими инфекционными болезнями. Менингококковый менингит дифференцируют с гнойными менингитами другой этиологии.
Лечение
При менингококковой инфекции необходима ранняя госпитализация в специализированные отделения инфекционной больницы. При развитии осложнений больных определяют в отделение реанимации. В случаях выраженной интоксикации, лихорадки назначают антибиотики. В тяжелых случаях проводят противошоковые мероприятия, дегидратационную и дезинтоксикационную, противосудорожную терапию. Назначают анальгетики, применяют кортикостероиды, оксигенотерапию, искусственную вентиляцию легких и другие средства. По показаниям используют витамины, ноотропные препараты и сердечные гликозиды. Выписка из стационара может быть произведена после исчезновения клинических симптомов, при наступлении выздоровления и отсутствии в бактериологических исследованиях слизи из зева и носа менингококков.
В большинстве случаев при своевременном лечении менингококковой инфекции прогноз благоприятен. По статистике летальные исходы возможны при таких осложнениях, как отек и набухание головного мозга, инфекционно-токсический шок. Остаточные явления встречаются у пациентов, лечение которых было начато только в поздние сроки заболевания. Могут быть функциональные нарушения нервно-психической деятельности. Пациентам, перенесшим менингококковую инфекцию показано амбулаторное наблюдение и долечивание у невролога.
В большинстве случаев при своевременном лечении менингококковой инфекции прогноз благоприятен. По статистике летальные исходы возможны при таких осложнениях, как отек и набухание головного мозга, инфекционно-токсический шок. Остаточные явления встречаются у пациентов, лечение которых было начато только в поздние сроки заболевания. Могут быть функциональные нарушения нервно-психической деятельности. Пациентам, перенесшим менингококковую инфекцию показано амбулаторное наблюдение и долечивание у невролога.
Профилактика
Важно вовремя поставить диагноз больным с разными видами менингококковой инфекции и госпитализировать их. Противоэпидемическими мерами является выявление носителей инфекции и проведение им санации носоглотки. Большое значение для профилактики имеет повышение иммунитета людей. За теми, кто был в контакте с больным, устанавливается медицинское наблюдение и проводится бактериологическое обследование. По показаниям осуществляется вакцинация комплексной полисахаридной вакциной против менингококков серологических групп А и С, иммунитет от которой сохраняется в течение 3-5 лет. Повторную иммунизацию при угрозе эпидемии можно проводить через три года.